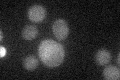
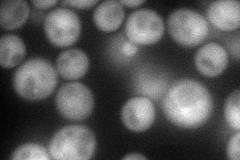
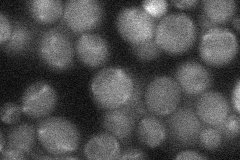

View description
Methionine-R-sulfoxide reductase, involved in the response to oxidative stress; protects iron-sulfur clusters from oxidative inactivation along with MXR1; involved in the regulation of lifespan
Localization:
Intensity:
Fold change:
Significance:
-
C’ GFP library in SD
below threshold19.34 -
N' NOP1pr-GFP in SD
cytosol119.127 -
N' TEF2pr-mCherry in SD

cell periphery,vacuole0 -
N' NATIVEpr-GFP in SD
below threshold20.292 -
N' TEF2pr-VC and Cyto-VN in SD

#N/A0 -
C’ GFP library in SD+DTT

cytosol14.310.73No -
C’ GFP library in SD+H2O2

cytosol16.280.84No -
C’ GFP library in Starvation Media

cytosol16.560.85No -
C’ GFP library on the background of Pup2-DaMP

below threshold -
C’ GFP library on the background of CCT mutant

below threshold19.32910.999365No
